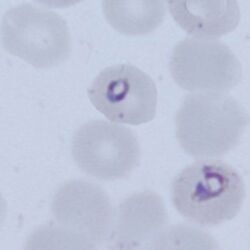

Plasmodium knowlesi: Morphology: Difference between revisions
From MalariaETC
No edit summary |
No edit summary |
||
| Line 60: | Line 60: | ||
<div style="width: 350px"> | <div style="width: 350px"> | ||
</br> | </br> | ||
'''GALLERY:''' | |||
[[P.knowlesi schizont gallery|''P.knowlesi'' schizonts]] | |||
---- | ---- | ||
</br><span style="font-size:110%">'''The gametocyte'''</span></br> | </br><span style="font-size:110%">'''The gametocyte'''</span></br> | ||
Revision as of 19:02, 7 February 2025
| Navigation |
| >Main malaria Index |
| >Main Species identification page |
Plasmodium knowlesi
Geographical distribution: Rarely seen, since it is acquired only from monkey host in forest or forest-fringe in S.E.Asia with no human to human spread. It is important to recognise this parasite however as travellers from affected areas may contract this species which has rapid division (each 24 hours) and may have high-parasitaemia with the potential for life threatening disease.
The early trophozoite
Early trophozoites will generally be present and broadly resemble P.falciparum.
- Ring forms are small and relatively fine (1/3 to 1/2 of erythrocyte diameter)
- Occasional forms are non-vacuolated and double dots may occur at opposite poles
- Multiple parasite infection of cells frequent, but accolé forms rare or absent
- No size change, stippling or pigment at this stage
GALLERY:
P.knowlesi early trophozoites
The late trophozoite
Late trophozoites are usually present and share features with either P.malariae or P.falciparum.
- May have a solid or band-form, but generally retain a vacuole
- Acquiring malaria pigment at late stages, may be separate or clumped
- Occasional sparse dots may seen (Sinton or Mulligan's stippling)
- Red cell size generally unaffected
GALLERY:
P.knowlesi late trophozoites
The schizont
Present in mast cases partly resemble an "untidy" P.malariae
- Up to 16 merozoites (a low number but exceeds P.malariae)
- Merozoites do not generally fill the erythrocyte, and may be irregular or grape-like.
- Erythrocyte not enlarged may be a irregular.
- Sinton or Mulligan's stippling may be seen.
GALLERY:
P.knowlesi schizonts
The gametocyte
---
- Gametocytes tend to be regular and round in shape.
- The parasites are small and do not generally fill the erythrocyte
- Haemoglobin is absent and pigment overlies the gametocyte -
| Click for GALLERY |